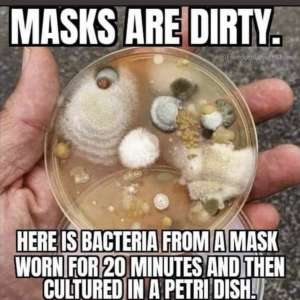
Image

All of these people wearing the masks are going to have pointy looking ears after awhile... Just sayin. And now they are suggesting double masking ? Can someone people teach these people basic science and the size of a virus VS the fabrics that are filled with bacteria that is strapped to their faces preventing them from releasing toxins meant to leave the body or taking in fresh oxygen ? Masks don't work and they weaken your immune system and make you sick... #UnMaskTheWorld #MAGA #wwg1wga
12:56 AM - Jan 28, 2021
Only people mentioned by 1221Dovetail in this post can reply
Carol Roberts
@InHisHolyName
29 January, 11:22
In response Dovetail 1221 to her Publication
Amen! I have posted time after time about this. But sheeple just keep on wearing them. As an RN I know the deleterious effect on the immune system. Handwashing is the most effective and proven method of restricting the spread of disease. So many constantly touch their masks with filthy hands. No wonder bacterial respiratory & sinus infections are increasing. Also facial acne, & facial skin inflammation. #UnMask
Notice: Undefined index: tg1tga_access in /home/admin/www/anonup.com/themes/default/apps/timeline/post.phtml on line 396
David Next
@David_Next_61
29 January, 10:10
In response Dovetail 1221 to her Publication
ive tried, it falls on deaf ears.
Notice: Undefined index: tg1tga_access in /home/admin/www/anonup.com/themes/default/apps/timeline/post.phtml on line 396
Texas Cowgal
@Texascowgal
28 January, 01:19
In response Dovetail 1221 to her Publication
Notice: Undefined index: tg1tga_access in /home/admin/www/anonup.com/themes/default/apps/timeline/post.phtml on line 396
28 January, 01:24
In response Texas Cowgal to her Publication
Thats is creepy ! 👀 lol
Notice: Undefined index: tg1tga_access in /home/admin/www/anonup.com/themes/default/apps/timeline/post.phtml on line 396
Kindred Spirit
@OccamsRazQr
28 January, 01:17
In response Dovetail 1221 to her Publication
Notice: Undefined index: tg1tga_access in /home/admin/www/anonup.com/themes/default/apps/timeline/post.phtml on line 396
28 January, 01:20
In response Kindred Spirit to her Publication
These are an awesome share thank you!!! 🙏🏼❤️✝️❤️🙏🏼
Notice: Undefined index: tg1tga_access in /home/admin/www/anonup.com/themes/default/apps/timeline/post.phtml on line 396
28 January, 01:15
In response Dovetail 1221 to her Publication
Notice: Undefined index: tg1tga_access in /home/admin/www/anonup.com/themes/default/apps/timeline/post.phtml on line 396
28 January, 01:16
In response BeaglesSay,... Biden crime family to her Publication
Exactly!!! Or even a BB going thru a chain link fence is what B tell people! I love this though!!! Thank you for sharing 🙏🏼❤️✝️❤️🙏🏼
Notice: Undefined index: tg1tga_access in /home/admin/www/anonup.com/themes/default/apps/timeline/post.phtml on line 396
Lauren McIntyre
@Lomac
28 January, 01:13
In response Dovetail 1221 to her Publication
biology 101.... 🤦♀️
Notice: Undefined index: tg1tga_access in /home/admin/www/anonup.com/themes/default/apps/timeline/post.phtml on line 396
28 January, 01:15
In response Lauren McIntyre to her Publication
Exactly...
Notice: Undefined index: tg1tga_access in /home/admin/www/anonup.com/themes/default/apps/timeline/post.phtml on line 396
Bob Enslow
@cmbwsu
28 January, 01:07
In response Dovetail 1221 to her Publication
Notice: Undefined index: tg1tga_access in /home/admin/www/anonup.com/themes/default/apps/timeline/post.phtml on line 396
28 January, 01:14
In response Bob Enslow to his Publication
Thank you for sharing! 🙏🏼❤️✝️❤️🙏🏼
Notice: Undefined index: tg1tga_access in /home/admin/www/anonup.com/themes/default/apps/timeline/post.phtml on line 396